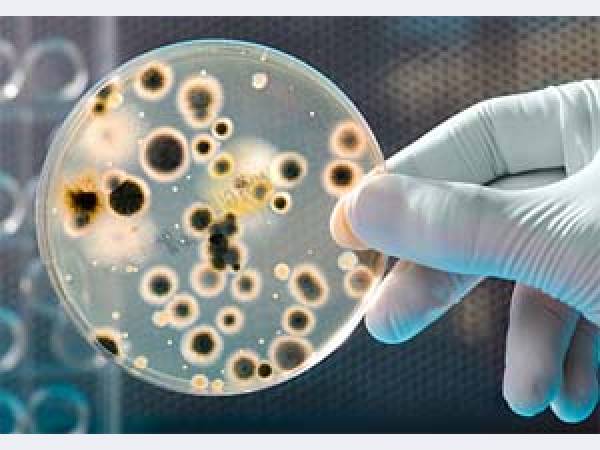

Metaprom.ru / Каталог поставщиков / Нефтепродукты, топливо, ГСМ / Нефтепродукты, топливо, ГСМ в Нижегородской области / Аврора-НН, РДЦ, ООО
Аврора-НН, РДЦ, ООО
Аврора-НН, РДЦ, ОООООО РДЦ «АВРОРА-НН» реализует продукцию - СОЖ "Акватек" и "Техмол".
Подробное описание
ООО РДЦ «АВРОРА-НН» реализует со своего склада в г. Н. Новгород смазочно-охлаждающие жидкости (СОЖ) для металлообработки, Смазки, Масла индустриальные
Подробные технические описания и условия эксплуатации СОЖ смотрите на нашем сайте.
Фасовка: канистры, бидоны, бочки, кубы. Отгружаем комплексные заявки по СОЖ, маслам и смазкам. Проведение производственных испытаний. Экспертная помощь в проблемах с охлаждением и смазкой при механической металлообработке.
Контактное лицо в Нижнем Новгороде по продукции Осокин Олег Владимирович
Основное направление
Нефтепродукты, топливо, ГСМ
Предлагаемая продукция, услуги
ООО РДЦ «АВРОРА-НН» реализует со своего склада в г. Н. Новгород смазочно-охлаждающие жидкости (СОЖ) для металлообработки, Смазки, Масла индустриальные
Подробные технические описания и условия эксплуатации СОЖ смотрите на нашем сайте.
Фасовка: канистры, бидоны, бочки, кубы. Отгружаем комплексные заявки по СОЖ, маслам и смазкам. Проведение производственных испытаний. Экспертная помощь в проблемах с охлаждением и смазкой при механической металлообработке.
| Регион | Россия / Нижегородская область / Нижний Новгород |
| Адрес | Нижний Новгород |
| Телефон | (831) 262-14-68, +7 915-943-22-81 |
| Сайт | avrora-nn.ru |
| ИНН | Не указан |
| Контактное лицо | Осокин Олег Владимирович |
Дата регистрации на портале: 07.05.2013
Посещаемость визитной карточки: всего 4519 | Март 14 | Апрель 11
|